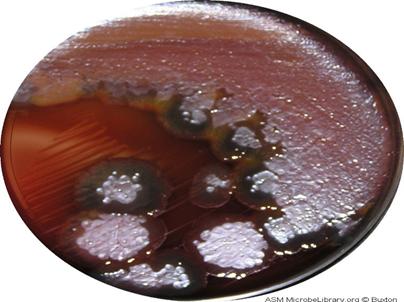

DIAGNOSTICUL DE LABORATOR AL INFECTIILOR PRODUSE PSEUDOMONAS AERUGINOSA
Genul Pseudomonas se clasifica in 11 genuri repartizate in 5 grupe de omologie de ARN ribozomal. Grupul I este reprezentat de pseudomonas cu speciile fluorescente (P.aeruginosa, P.putida, P. fluorescens), si speciile non-fluorescente (P.alcaligenes, P.pseudoalcaligenes, P. mendocina).
Specia pseudomonas aeruginosa (bacilul piocianic) este considerata saprofita conditionat patogena, oportunista fiind germenul tip al infectiilor intraspitalicesti.
Sunt bacterii larg raspandite in natura, intalniindu-se in apa, aer si sol. La om se intalneste pe tegumente, mucoase, in cavitatiile naturale si in tubul digestiv, ca saprofit.
Pseudomonas aeruginosa are o virulenta scazuta la persoanele competente imunologic deveniind un agent infectios periculos la pacientii imunodeprimanti (imunodepresie in boli cronice grave, diabet, neoplazii) sau la extremele de virsta (batranii si sugarii). Bacilul piocianic poate suprainfecta plagile chirurgicale cu aparitia unui puroi albastru verzui (denumirea bacteriei provine din limba greaca, pyon kyanos - puroi albastru). La nivelul tegumentelor poate provoca suprainfectarea arsurilor; poate produce infectii respiratorii, ale cailor urinare, infectii ORL (otite, sinuzite), infectii ale tubului digestiv, septicemii, meningite, endocardite.
Caractere morfologice
Bacili gram negativi, mobili, cu flageli cu localizare polara, nesporulati, necapsulati. Bacilii sunt usor incurbati sau pot prezenta forme scurte granulare (in culturi vechi) sau forme lungi filamentoase (in culturi tinere).

P.aeruginosa - aspecte de microscopie electronica

P.aeruginosa - aspecte de microscopie electronica

P. aeruginosa - coloratie gram
Caractere de cultura
Sunt bacterii aerobe, nepretentioase ce se pot dezvolta pe medii de cultura simple (bulion sau geloza simpla), precum si pe geloza sange, AABTL, Mac Conkey.
Prin cultivarea in bulion se observa cresterea bacilului prin aparitia turbuditatii mediului si aparitia unei membrane cenusii la suprafata, aderenta la peretii eprubetei. Dupa incubare 24h mediul devine vascos, deasupra formandu-se o membrana sub care se aduna pigmentul albastru verzui si se degaja un miros caracteristic de flori de salcim (miros datorat trimetilaminei, metabolit intermediar elaborat de bacilul piocianic). Pe geloza simpla pot apare colonii de mai multe tipuri: colonii mari de 2-3 mm diametru, de tip S margini regulate, suprafata granulara; colonii mici de tip S; colonii de tip R cu suprafata aspra rugoasa; colonii de tip M cu aspect mucos; colonii mici ce apar tardiv (72h) la pacientii cu mucoviscioza. Coloniile au reflexe metalice, iar diferitii pigmenti secretati de P.aeruginosa (piocianina de culoare albastra, fluoresceina de culoare galben fluorescent) dau culturii si respectiv mediului culoarea pigementilor, deoarece acstia sunt hidrosolubili. Pe geloza sange coloniile sunt lucioase, gri, cu aspect metalic, hemolitice. Pe AABTL si Mac Conkey apar colonii mici semitrasparente lactozo-negative.
P.aeruginosa - cultura pe geloza sange (sursa ASM MicrobelLibrary. Org Boston)
Caractere biochimice
Reactia oxidazei este pozitiva, testul catalazei este pozitiv; pe mediile politrope TSI si MIU nu fermenteza lactoza si zaharoza, oxideaza glucoza, nu produce H2S, reactia indol negativa, ureeaza negativa, nu hidrolizeaza exculina, utilizeaza citratul ca unica sursa de carbon, reactia Voges - Proskauer si rosu metil negative.
Identificarea se poate face cu ajutorul sistemelor standardizate si miniaturizate (sistem API).
Antibiograma - este obligatorie datorita sensibilitatii varialbile a tulpinilor. Se poate realiza prin metoda difuzimetrica sau cu ajutorul sistemului standardizat si miniaturizat API.
Bacilul piocianic este genetic rezistent la penicilinele de grup A, la unele cefalosporine. Printre antibioticele eficiente putem enumera beta-lactaminele (aztreonam, imipenem, ceftazidim), aminoglicozidele si grupul quinelonelor.
|
Politica de confidentialitate |
| Copyright ©
2025 - Toate drepturile rezervate. Toate documentele au caracter informativ cu scop educational. |
Personaje din literatura |
| Baltagul – caracterizarea personajelor |
| Caracterizare Alexandru Lapusneanul |
| Caracterizarea lui Gavilescu |
| Caracterizarea personajelor negative din basmul |
Tehnica si mecanica |
| Cuplaje - definitii. notatii. exemple. repere istorice. |
| Actionare macara |
| Reprezentarea si cotarea filetelor |
Geografie |
| Turismul pe terra |
| Vulcanii Și mediul |
| Padurile pe terra si industrializarea lemnului |
| Termeni si conditii |
| Contact |
| Creeaza si tu |